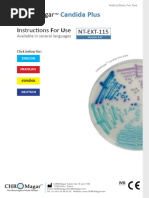
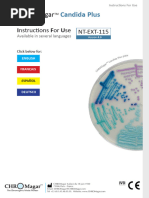
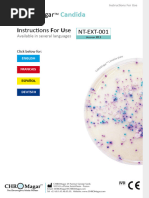

INSTRUCTIONS FOR USE –
READY-TO-USE PLATED
MEDIA
PA-255002.05 Rev.: Sep 2011
BD BiGGY Agar (Bismuth Glucose Glycine Yeast Agar)
INTENDED USE
BD BiGGY Agar is a partially selective and differential medium for the isolation and
differentiation of Candida species from clinical specimens.
PRINCIPLES AND EXPLANATION OF THE PROCEDURE
Microbiological method.
BiGGY Agar is a modification of the Nickerson medium.1 During the study of the sulfite
reduction of Candida species, Nickerson detected differences in this ability between the Candida
species. He described this medium for the isolation of Candida albicans which can be
differentiated from other Candida species by means of colony colour and morphology.2
In BD BiGGY Agar, yeast extract and glucose provide the nutrients necessary for yeast growth.
Glycine is an additional nutrient, but also inhibits many bacterial species at the high
concentration used in this medium. Candida species, through a process of substrate reduction,
reduce the bismuth salt to bismuth and sulfite to sulfide. Bismuth and sulfide combine to a
brownish to black precipitate which stains the colonies and may diffuse into the medium. Also,
the bismuth and sulfur compounds are inhibitory to many bacteria.
REAGENTS
BD BiGGY Agar
Formula* Per Liter Purified Water
Bismuth Ammonium Citrate 5.0 g
Sodium Sulfite 3.0
Glucose 10.0
Glycine 10.0
Yeast Extract 1.0
Agar 16.0
pH 6.8 +/- 0.2
*Adjusted and/or supplemented as required to meet performance criteria.
PRECAUTIONS
. For professional use only.
Do not use plates if they show evidence of microbial contamination, discoloration, drying,
cracking or other signs of deterioration.
Consult GENERAL INSTRUCTIONS FOR USE document for aseptic handling procedures,
biohazards, and disposal of used product.
STORAGE AND SHELF LIFE
On receipt, store plates in the dark at 2 to 8° C, in their original sleeve wrapping until just prior to
use. Avoid freezing and overheating. The plates may be inoculated up to the expiration date
(see package label) and incubated for the recommended incubation times.
Plates from opened stacks of 10 plates can be used for one week when stored in a clean area
at 2 to 8° C.
USER QUALITY CONTROL
Inoculate representative samples with the following strains (for details, see GENERAL
INSTRUCTIONS FOR USE document). Incubate the plates for 48 to 72 hours at 25 to 28° C.
PA-255002.05 -1-
�Strains Growth Results
Candida albicans Colonies brown-red, or creme with brown center; no sheen
ATCC 60193
Candida glabrata ATCC 2001 Light brown colonies
Candida krusei ATCC 34135 Large flat, reddish-brown colonies with silvery black top,
brown edge and yellowish halos
Candida tropicalis Brown colonies with black centers and sheen, diffuse
ATCC 1369 blackening of the surrounding medium (often only after 72 h
of incubation)
Escherichia coli ATCC 25922 Inhibition partial to complete; beige colonies
Pseudomonas aeruginosa Inhibition partial to complete; beige colonies
ATCC 27853
Staphylococcus aureus Inhibition partial to complete; white colonies
ATCC 25923
Uninoculated Whitish to light amber, opalescent with a slightly flocculent
precipitate
PROCEDURE
Materials Provided
BD BiGGY Agar (90 mm Stacker plates). Microbiologically controlled.
Materials Not Provided
Ancillary culture media, reagents and laboratory equipment as required.
Specimen Types
This medium is used for the isolation and differentiation of Candida species from all types of
clinical specimens (see also PERFORMANCE CHARACTERISTICS AND LIMITATIONS OF
THE PROCEDURE).
Test Procedure
Streak the specimen as soon as possible after it is received in the laboratory. The streak plate is
used primarily to isolate pure cultures from specimens containing mixed flora. Alternatively, if
material is being cultured directly from a swab, roll the swab over a small area of the surface at
the edge; then streak from this inoculated area.
Incubate the plates aerobically for at least 48 hours and not longer than 5 days, at 30 +/2° C.
The inoculation of other fungal media, e.g., BD Sabouraud Glucose Agar or BD
CHROMagar Candida Medium, and media for the detection of bacteria is recommended to
provide an indication of all pathogens present in the specimen.
Results
After the incubation, the appearance of the organisms will be as follows:
Candida albicans Brown red to black colonies, no pigment diffusion into the medium; no
sheen
C. tropicalis Dark brown colonies with black centers and sheen, diffuse blackening
of the surrounding medium (often only after 72 h of incubation)
C. krusei Large flat reddish-brown colonies with silvery black top, brown edge
and yellowish halos
C. pseudotropicalis Large, reddish-brown colonies, flat with mycelial fringe
Candida glabrata Pale to light brown colonies
Further tests are necessary for confirmation of the presumptive identification obtained on this
medium.3
PA-255002.05 -2-
�PERFORMANCE CHARACTERISTICS AND LIMITATIONS OF THE PROCEDURE
BD BiGGY Agar is a selective and differential medium for the isolation and differentiation of
Candida species from clinical specimens.4-6 Accompanying bacterial flora is partially to
completely inhibited on this medium.
Yeasts other than Candida and certain filamentous fungi may grow on this medium, but can be
differentiated by different appearance on this medium.
For a final identification of the species isolated, additional biochemical and morphological tests
are needed. Identification of Candida albicans, C. krusei, and C. tropicalis may be performed by
using BD CHROMagar Candida Medium. For other species, complete biochemical
identification is necessary.
Certain bacteria may grow on BD BiGGY Agar and produce a brownish precipitate. They can be
differentiated by microscopic examination.
Plates must not be incubated longer than 5 days since this may cause false positives.
REFERENCES
1. Nickerson, W. J. 1947. Biology of pathogenic fungi. The Chronica Botanica Co., Waltham,
MA. USA.
2. Nickerson, W. J. 1953. Reduction of inorganic substances by yeasts. I. Extracellular
reduction of sulfite by species of Candida. J. Infect. Dis. 93:43.
3. Warren, N. G., and K. C. Hazen. 1995. Candida, Cryptococcus, and other yeasts of medical
importance, p. 723-737. In P. R. Murray, E. J. Baron, M. A. Pfaller, F. C. Tenover and R. H.
Yolken (ed.)., Manual of clinical microbiology, 6th ed. American Society for Microbiology,
Washington, D.C.
4. MacFaddin, J. D. 1985. Media for isolation – cultivation – identification - maintenance of
medical bacteria, vol. 1, p. 65-68. Williams & Wilkins, Baltimore, MD.
5. Atlas, R.M. 1993. Handbook of microbiological media. CRC Press, Boca Raton, FL, USA.
6. Larocco, M.T. 2003. Reagents, stains, and media: mycology. In: Murray, P. R., E. J. Baron,
J.H. Jorgensen, M. A. Pfaller, and R. H. Yolken (ed.). Manual of clinical microbiology, 8th
ed. American Society for Microbiology, Washington, D.C.
PACKAGING/AVAILABILITY
BD BiGGY Agar
Cat. No. 255002 Ready-to-use Plated Media, cpu 20
FURTHER INFORMATION
For further information please contact your local BD representative.
Becton Dickinson GmbH
Tullastrasse 8 – 12
D-69126 Heidelberg/Germany
Phone: +49-62 21-30 50 Fax: +49-62 21-30 52 16
Reception_Germany@europe.bd.com
http://www.bd.com
http://www.bd.com/europe/regulatory/
CHROMagar is a trademark of Dr. A. Rambach
ATCC is a trademark of the American Type Culture Collection
BD, BD Logo and all other trademarks are property of Becton, Dickinson and Company. © 2011 BD
PA-255002.05 -3-